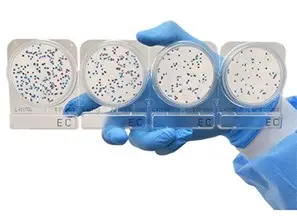
Compact Dry Ec Plate

צלחות פטרי Compact Dry
הפתרון החדש בבדיקות מיקרוביאליות — פשוט, מהיר ומדויק
קומפקט דריי הוא דור מתקדם של מצעי תרבית מוכנים לשימוש, המאפשר ביצוע בדיקות מיקרוביאליות במהירות, בפשטות ובאמינות גבוהה — ללא צורך בהכנת אגר וללא מיומנות מיקרוביולוגית מיוחדת.
למה לבחור קומפקט דריי?
- שימוש קל במיוחד — טיפה אחת וזהו
אין צורך לפתוח שכבות, למרוח או לפזר את הדגימה. פשוט מטפטפים למרכז — והנוזל מתפזר מעצמו בצורה אחידה.
- תוצאות מדויקות ועקביות
הפיזור האוטומטי מבטל טעויות אנוש ומבטיח ספירת מושבות אחידה ואמינה בין מפעילים שונים.
- מתאים גם לדגימות קשות
עובד היטב עם דגימות עכורות, שומניות או עם חלקיקים — תחומים שבהם מצעים שטוחים ודקים מתקשים.
- סיכון מופחת לזיהום
אין צורך לפתוח ולסגור שכבות — המגע עם הסביבה מינימלי.
- אידיאלי לעבודה בשטח וב-QC
מתאים למפעלי מזון, מים, חקלאות, מעבדות שירות ובדיקות היגיינה.
- ספירה קלה וברורה
מבנה קשיח עם רשת ספירה מודפסת ומושבות בולטות.
- אמינות גבוהה גם ללא צוות מיקרוביולוגי
מצוין לצוותי ייצור, אחזקה ובקרת איכות.
יישומים נפוצים
- ספירה כללית (Total Count)
- קוליפורמים וE. coli
- שמרים ועובשים
- בדיקות היגיינה למשטחים
- מים לשתייה, תעשייה וחקלאות
- מזון ומשקאות
מתי זה הפתרון המועדף?
- כאשר נדרש תהליך פשוט ומהיר
- כאשר עובדים עם מפעילים רבים
- כאשר הדגימות אינן צלולות
- כאשר רוצים להפחית טעויות תפעול
- כאשר אין מעבדה מיקרוביולוגית מלאה